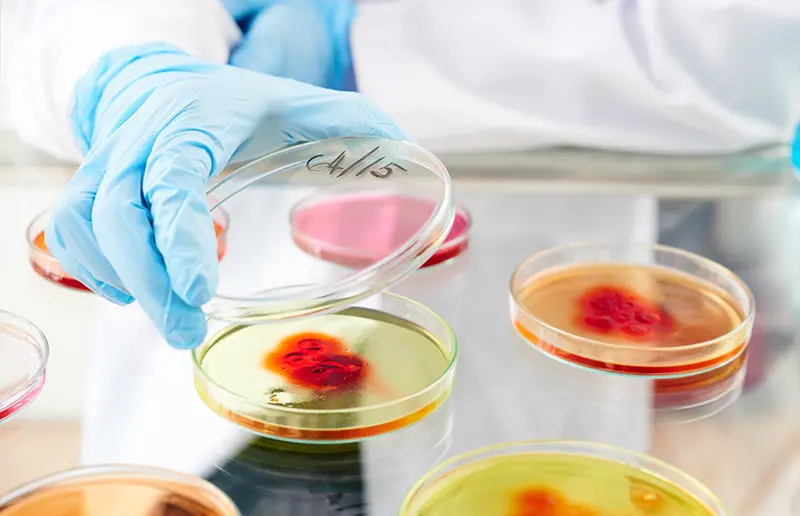
these low-cost, reliable pipeyye pumps are used primarily in 5 settings biological research

Scilogex Pipette Pump Pipette Fillers
Pipette pump for applications where electronic alternatives aren’t justified due to throughput or budget
Precise
Simple
Reliable
Low-costPipette pump for applications where electronic alternatives aren’t justified due to throughput or budget
Precise
Simple
Reliable
Low-costThese low-cost, reliable pipette pumps are used primarily in 5 settings.

Educational labs
Teaching students accurate liquid handling techniques, given the low cost and simplicity of manual pumps.
Biological research
Transferring cell cultures, preparing solutions, or working with reagents for molecular biology assays.

Quality control labs
Measuring and transferring precise quantities of solutions for consistency in testing.

Clinical diagnostics
Handling patient samples or reagents in tests, especially where contamination control is important.

Chemical and environmental testing
Preparing standards and reagents or when diluting samples.
These low-cost, reliable pipette pumps are used primarily in 5 settings.

Teaching students accurate liquid handling techniques, given the low cost and simplicity of manual pumps.

Transferring cell cultures, preparing solutions, or working with reagents for molecular biology assays.
Measuring and transferring precise quantities of solutions for consistency in testing.

Clinical diagnostics
Handling patient samples or reagents in tests, especially where contamination control is important.

Handling patient samples or reagents in tests, especially where contamination control is important.

Chemical and environmental testing
Preparing standards and reagents or when diluting samples.

Preparing standards and reagents or when diluting samples.
Get more mileage from your pipette pump
Most low-cost pipette pumps give you 1-3 years of service before you’re burdened with replacing them.
Scilogex serological pipette pumps last an average of 5 years in the common applications listed above.
It’s a small cost, but it adds up. Save yourself the hassle of replacing your pipette pump in a short period of time by choosing a longer-lasting, reliable pump.
Average lifespan - 5 years
Level of use - moderate
Maintenance requirements - low
Need to supplement your pipette pumps with additional tools?
Most labs use multiple instruments for various SOPs. Get everything you need in a single order and reduce the logistical burden of keeping your lab supplied.
Need to supplement your pipette pumps with additional tools?
Most labs use multiple instruments for various SOPs. Get everything you need in a single order and reduce the logistical burden of keeping your lab supplied.
Meeting the challenges of low-cost, low-to-medium-volume liquid handling
Scilogex pipette pumps address common user challenges with practical benefits that make daily lab tasks easier and more accurate.
Accuracy matters in every measurement. Scilogex serological pipette pumps allow your team to confidently handle small liquid volumes without blowout (retaining the last drop). This precision reduces the risk of error, helping technicians with repeatability and accuracy.
When your day involves repetitive liquid transfers, comfort is key. With an ergonomic design and intuitive controls, Scilogex pipette pumps reduce hand strain and fatigue, letting users work comfortably even during high-volume tasks. This streamlined handling is particularly helpful in clinical and research settings where efficiency and comfort can improve workflow.
Labs often juggle multiple pipette types, and the pipette pump is designed to fit a variety of serological pipettes seamlessly. This compatibility helps users avoid interruptions and handle different volumes without needing separate tools, saving time and money.
Lab equipment takes a lot of wear and tear, and the pipette pump is built to last. Made with durable materials, it withstands daily use, providing a dependable, low-cost solution that reduces the need for frequent replacements. This durability is a benefit that lab managers appreciate as it supports long-term budget management.
Frequently asked questions about pipette pumps and serological pipette pumps
A pipette pump is a laboratory tool used for the precise aspiration and dispensing of liquids. Designed for use with serological and volumetric pipettes, it offers both speed and control over liquid handling tasks. Pipette pumps are often manually operated, using thumb controls to draw liquid into the pipette and release it. They are popular in labs for applications where accuracy and ease of liquid transfer are essential.
Pipette pumps come in various types to meet different needs:
- Manual pipette pumps are operated by hand, using a thumbwheel or lever to control liquid transfer. They are cost-effective and easy to use, especially for general lab applications.
- Electronic pipette controllers allow for faster liquid handling and finer control with their battery-powered motors. They are ideal for high-throughput labs or tasks that require repetitive pipetting.
- Motorized pipette fillers are similar to electronic controllers and use a motor to assist in aspiration and dispensing. They’re high precision and easy to use, often with adjustable speed settings.
A serological pipette pump is specifically designed to work with serological pipettes, which are marked with graduated volume measurements along their length. Serological pipette pumps ensure that the liquid levels align with the graduations on the pipette, giving accurate measurements across a range of volumes. Other pipette pumps may be suitable for a wider range of pipettes, but serological pipette pumps are optimized to deliver precision for this specific type.
To use a pipette pump with a serological pipette:
- Attach the serological pipette firmly into the pump’s holder or chuck, ensuring a secure fit.
- Use the thumbwheel or lever to draw liquid into the pipette. Turn or press the control slowly to avoid splashing.
- For precise dispensing, adjust the thumbwheel or lever carefully to release the liquid at the desired rate.
- When finished, remove the pipette gently to avoid breaking or spilling. This simple process makes the pipette pump easy to use even for beginners, while the manual controls allow for fine-tuning liquid levels.
Pipette pumps are widely used in:
- Clinical labs: Handling patient samples and reagents for diagnostic testing.
- Research labs: Preparing solutions, handling reagents, and performing experimental assays.
- Quality control: Ensuring consistent measurements for product testing.
- Environmental testing: Collecting and preparing samples for analysis.
- Educational labs: Training students in basic pipetting techniques. These applications span many fields due to the pipette pump’s versatility and reliability in liquid handling tasks.
Volume capacity
Ensure the pump can handle the volume range you typically work with. Manual pumps are available for different capacities, often color-coded by size.
Manual vs electronic
For basic tasks, a manual pump is cost-effective and straightforward. For repetitive or high-precision tasks, consider an electronic or motorized controller.
Compatibility
Confirm the pump is compatible with the pipette type you’re using, especially if working with serological pipettes.
Regular maintenance of a pipette pump involves:
- After each use, disassemble the pump if possible and clean each part with mild detergent to remove any residue.
- Rinse with distilled water and let the parts air dry completely before reassembly.
- Periodically check seals, gaskets, or moving parts for wear or damage, replacing them as needed.
- If contamination is a concern, sterilize the pump parts based on the lab’s protocols, especially if handling biological samples. Proper cleaning and maintenance ensure the pump’s longevity and accuracy.
For safe use of a pipette pump:
- Wear protective equipment. Always wear gloves, goggles, and lab coats to protect against splashes.
- Avoid overfilling. Draw liquids slowly to prevent overflow, which can lead to spills or contamination.
- Clean after use. Prevent cross-contamination by cleaning the pump between uses, especially when switching between different solutions.
- Inspect for damage. Before use, check the pump for any signs of wear, such as cracks or loose parts, which can compromise performance. Following these precautions will help ensure safe and accurate handling.
A pipette pump provides precise control over liquid aspiration and dispensing, reducing the risk of inconsistent measurements. The manual or electronic controls allow users to fine-tune volumes, achieving accurate results consistently. This precision is especially beneficial in clinical and research settings, where reproducibility is crucial. By offering stable, repeatable measurements, pipette pumps help labs maintain accuracy and quality in their processes.
Limit lid openings, keep the dewar in a cool area, and ensure the neck/lid is sealed properly after each use. Good insulation and minimal exposure to ambient air are key.
Additional Resources and Information
Downloadable PDFs
Additional Resources and Information
Downloadable PDFs
Ordering Information:
Cat. No.:
740300019999
Color :
Blue
Volume Range :
Up to 2ml
Cat. No.:
740300019999
Color :
Blue
Volume Range :
Up to 2ml
Cat. No.:
740300029999
Color :
Green
Volume Range :
Up to 10ml
Cat. No.:
740300029999
Color :
Green
Volume Range :
Up to 10ml
Cat. No.:
740300039999
Color :
Red
Volume Range :
Up to 25ml
Cat. No.:
740300039999
Color :
Red
Volume Range :
Up to 25ml
Product Accessories
Our latest content
Check out what's new in our company !
View our 2025 Product Catalog
Get our complete and latest product portfolio for free.
Earn Rewards
Enjoy exclusive deals & discounts on our lab equipment & supplies.
Download Scilogex Literature
Find a collection of product manuals and brochure PDFs available for download.

